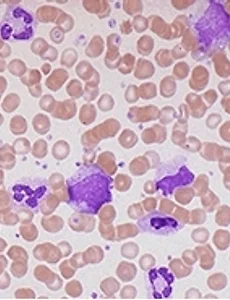

혈핵학-전염단핵구증과 림프구 증식질환의 감별 진단
1. 임상적 특징 비교: 증상, 징후, 역학▶ 전염단핵구증(Infectious Mononucleosis, IM)원인: Epstein-Barr virus(EBV) 초감염 (90% 이상), 드물게 CMV, HIV 등주요 증상:삼중 증상: 발열(38~40°C, 1~2주 지속), 심한 인후통(화농성 없음), 피로감(4주 이상 지속 가능)림프절 종대: 양측성 경부 림프절(후부 우세), 압통 동반, 직경 2cm 이하비장비대: 50%에서 발생, 비장 파열 위험(0.1~0.5%)간염: 80~90%에서 AST/ALT 상승, 5%에서 황달피부 발진: Ampicillin 투여 시 80%에서 발적성 발진역학: 15~25세 청소년/청년층 호발, 90% 이상 성인에서 항체 양성▶ 림프구 증식질환(LPD)종류: 호지킨림프종, 비호..
2025. 5. 12.
혈핵학-전염단핵구증과 림프구 증식질환의 감별 진단
1. 임상적 특징 비교: 증상, 징후, 역학▶ 전염단핵구증(Infectious Mononucleosis, IM)원인: Epstein-Barr virus(EBV) 초감염 (90% 이상), 드물게 CMV, HIV 등주요 증상:삼중 증상: 발열(38~40°C, 1~2주 지속), 심한 인후통(화농성 없음), 피로감(4주 이상 지속 가능)림프절 종대: 양측성 경부 림프절(후부 우세), 압통 동반, 직경 2cm 이하비장비대: 50%에서 발생, 비장 파열 위험(0.1~0.5%)간염: 80~90%에서 AST/ALT 상승, 5%에서 황달피부 발진: Ampicillin 투여 시 80%에서 발적성 발진역학: 15~25세 청소년/청년층 호발, 90% 이상 성인에서 항체 양성▶ 림프구 증식질환(LPD)종류: 호지킨림프종, 비호..
2025. 5. 12.
혈핵학-말초혈액 도말 검사를 통한 백혈구 이상 형태 식별법
1. 말초혈액 도말 검사의 원리와 임상적 중요성말초혈액 도말 검사는 혈액 내 세포의 형태학적 이상을 직접 관찰하여 다양한 혈액 질환을 진단하는 데 필수적인 검사입니다. 이 검사는 자동혈구분석기에서 확인할 수 없는 세포의 미세한 형태 변화를 파악할 수 있어, 특히 백혈구(WBC) 이상 감별에 큰 역할을 합니다.슬라이드에 소량의 혈액을 얇게 펴고 Wright-Giemsa 염색을 한 뒤, 현미경으로 관찰하면 각 백혈구의 크기, 핵의 모양, 세포질의 색과 과립 등 다양한 세포학적 특징을 평가할 수 있습니다. 말초혈액 도말 검사는 급성 감염, 만성 염증, 혈액암(백혈병, 림프종), 골수이형성증후군(MDS) 등에서 백혈구의 비정상적 변형을 조기에 발견하는 데 매우 유용합니다. 또한, 약물 부작용, 자가면역질환, ..
2025. 5. 12.
혈핵학-말초혈액 도말 검사를 통한 백혈구 이상 형태 식별법
1. 말초혈액 도말 검사의 원리와 임상적 중요성말초혈액 도말 검사는 혈액 내 세포의 형태학적 이상을 직접 관찰하여 다양한 혈액 질환을 진단하는 데 필수적인 검사입니다. 이 검사는 자동혈구분석기에서 확인할 수 없는 세포의 미세한 형태 변화를 파악할 수 있어, 특히 백혈구(WBC) 이상 감별에 큰 역할을 합니다.슬라이드에 소량의 혈액을 얇게 펴고 Wright-Giemsa 염색을 한 뒤, 현미경으로 관찰하면 각 백혈구의 크기, 핵의 모양, 세포질의 색과 과립 등 다양한 세포학적 특징을 평가할 수 있습니다. 말초혈액 도말 검사는 급성 감염, 만성 염증, 혈액암(백혈병, 림프종), 골수이형성증후군(MDS) 등에서 백혈구의 비정상적 변형을 조기에 발견하는 데 매우 유용합니다. 또한, 약물 부작용, 자가면역질환, ..
2025. 5. 12.